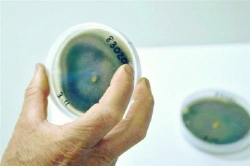
giu co2 trong dat la mot cong cu chong lai bien doi khi hau

Tạp chí Sức khỏe và Môi trường điện tử - Kết quả tìm kiếm cho từ khóa "L C", chúc bạn tìm được nội dung mong muốn trên Tạp chí Sức khỏe và Môi trường điện tử

TP.HCM: Tiêm filer làm đầy rãnh má, mặt thiếu nữ sưng phù, mưng mủ
(SK&MT) - Sau khi tiêm 1ml chất làm đầy (hay còn gọi là filer) với giá 3.5 triệu đồng cho 2 bên rãnh mũi, má ở một viện thẩm mỹ tại quận 1, TP.HCM, thiếu nữ L.N.L.K (26 tuổi, ngụ quận Bình Tân) cảm thấy đau nhói, cơn đau kéo dài và vài ngày tiếp theo mặt sưng phù, mưng mủ.
Giữ CO2 trong đất là một công cụ chống lại biến đổi khí hậu
(SK&MT) - Công ty Soil Carbon của Australia đang phát triển một phương pháp cho phép cây cối hấp thụ carbon nhiều hơn bình thường. Cách làm này có thể giúp đất nông nghiệp hiện có hấp thụ được hàng tỷ tấn CO2/năm.

Mưa lớn có nguyên nhân từ biến đổi khí hậu
(SK&MT) - Ngày 4/8, chính quyền thành phố Seoul của Hàn Quốc cho biết những trận mưa lớn kéo dài nhiều ngày tại đây đã làm chết ít nhất 13 người, buộc hơn 1.000 người phải sơ tán và 13 người khác bị mất tích. Ngoài ra, 5.751 hécta đất nông nghiệp cũng bị ngập trong nước. Hàng nghìn tài sản cá nhân và công trình công cộng bị hư hỏng do ngập nước, ảnh hưởng tới hoạt động vận tải đường bộ và đường sắt.

Israel cân nhắc tái phong tỏa đất nước
(SK&MT) - Phát biểu tại phiên họp nội các ngày 31/5, Thủ tướng Israel Benjamin Netanyahu cho biết đang cân nhắc có thể áp đặt trở lại lệnh phong tỏa đất nước lần nữa trong bối cảnh tình trạng lây lan của đại dịch COVID-19 trong cộng đồng vẫn đang diễn ra.

Thành tích của Việt Nam trong cuộc chiến chống virus SARS-CoV-2 là “độc nhất vô nhị”
(SK&MT) - Tờ Globe and Mail của Canada ngày 27/5 đăng bài đánh giá “thành tích của Việt Nam trong cuộc chiến chống virus SARS-CoV-2 là đặc biệt nổi bật, có thể nói là độc nhất vô nhị” và gọi đây là “chuẩn mực trong cuộc chiến chống dịch viêm đường hô hấp cấp COVID-19."

Khánh Hòa: 75 doanh nghiệp tham gia chương trình kích cầu ngành Du lịch năm 2020
(SK&MT) - Sáng ngày 22/5/2020 tại Vinpearl Condotel Beachfront Nha Trang, Sở Du lịch Khánh Hòa phối hợp với Sở Thông tin và Truyền thông Khánh Hòa cùng Hiệp hội Du lịch Nha Trang - Khánh Hòa tổ chức họp báo công bố chương trình kích cầu ngành Du lịch Khánh Hòa năm 2020. Hiện đã có khoảng 75 doanh nghiệp (DN) tham gia chương trình kích cầu của ngành du lịch Khánh Hòa với 50 cơ sở lưu trú là các khách sạn, resort lớn, 13 khu, điểm du lịch, 10 công ty lữ hành và 1 đơn vị vận chuyển khách du lịch. Các DN thống nhất, mức giảm giá từ 20% – 50%, đồng thời vẫn đảm bảo chất lượng dịch vụ, sản phẩm.

Brazil đã vượt Anh để trở thành ổ dịch lớn thứ ba thế giới.
(SK&MT) - Với 262.545 trường hợp nhiễm virus corona chủng mới, Brazil đã vượt Anh để trở thành ổ dịch lớn thứ ba thế giới chỉ xếp sau Mỹ và Nga. Đến nay, Brazil ghi nhận 16.792 trường hợp chết vì COVID-19, là quốc gia có số người chết do dịch bệnh cao thứ 6 thế giới. Các chuyên gia cho rằng, số người chết và nhiễm virus tại Brazil có thể cao hơn trên thực tế khi nước này chưa thực hiện các xét nghiệm diện rộng.

Brazil có khả năng sẽ trở thành tâm dịch Covid-19 tiếp theo
Theo Worldometers, tính đến 6h ngày 4/5, thế giới ghi nhận thêm 80.714 người nhiễm dịch bệnh viêm đường hô hấp cấp Covid-19 do virus corona chủng mới (SARS-CoV-2) gây ra trong 24 giờ qua, nâng tổng số ca nhiễm bệnh lên 3.562.085. Số ca tử vong trên toàn cầu tính đến 6h ngày 4/5 là 248.086, tăng 3.423 trường hợp trong 24 giờ qua. Ngoài ra, số bệnh nhân Covid-19 được chữa khỏi đã vượt mốc 1,1 triệu, lên 1.153.033 ca, chiếm khoảng 1/3 số ca nhiễm.

Về việc viên bổ thảo mộc G-Star và L-Star Original chứa chất cấm: Trung tâm Quacert xác nhận
(SK&MT) - Trung tâm Chứng nhận phù hợp (Quacert) xác nhận, đã thực hiện xét nghiệm hai sản phẩm viên bổ thảo mộc G-Star, L-Star Original và cho ra kết quả có chứa chất cấm Phenolphthalein, Sibutramine.

Xung quanh việc viên giảm cân L-Star Original chứa chất cấm: Công ty Health Start phân phối hàng giả?
(SK&MT) - Lô hàng viên giảm cân L-Star đầu tiên được sản xuất ngày 2/1/2020, nhưng từ ngày 23/12/2019 sản phẩm này đã được chào bán rộng rãi trên mạng xã hội và sau đó bị phát hiện chứa chất cấm.

Sản phẩm tăng cân G-Star và giảm cân L-Star chứa chất cấm Sibutramine, Phenolphthaleine?
(SK&MT) - Sibutramine và Phenolphthalein là 2 hoạt chất Bộ Y tế nghiêm cấm sử dụng trong các loại thuốc giảm cân hiện nay. Tuy nhiên, sản phẩm tăng cân viên bổ thảo mộc G-Star và viên giảm cân L-Star Original của Công ty TNHH Health Star có chứa chất cấm này (theo Phiếu kết quả kiểm nghiệm từ Trung tâm Chứng nhận phù hợp - Quacert), vẫn được rao bán tràn lan, công khai trên thị trường.

Peugeot ưu đãi giá lên đến 50 triệu và nhiều quyền lợi hấp dẫn khác
SK&MT - Tháng 9/2019, Peugeot Việt Nam áp dụng nhiều chính sách hấp dẫn, bao gồm giá ưu đãi đặc biệt lên đến 50 triệu đồng dành cho hai mẫu xe Peugeot 3008 và Peugeot Traveller, ưu đãi 25 triệu đồng với riêng Peugeot 5008 cùng chương trình “Chăm sóc khách hàng toàn diện - Peugeot Total Care”.

Giải BRG Golf Hà Nội Festival 2019 thúc đẩy du lịch gôn Việt Nam
SK&MT - Không chỉ là dịp phô diễn các kỹ năng trong môn thể thao gôn, BRG Golf Hà Nội Festival còn là dịp lý tưởng để khách du lịch quốc tế khám phá Việt Nam qua gôn và tận hưởng tiết trời thu Hà Nội đẹp nhất trong năm.

Đồng bằng sông Cửu Long thiếu nước, xâm nhập mặn gia tăng
SK&MT – Theo Trung tâm Dự báo Khí tượng Thủy văn Quốc gia, năm nay tình trạng thiếu nước và xâm nhập mặn tại Đồng bằng sông Cửu Long (ĐBSCL) đến sớm hơn so với mọi năm. Các địa phương ở ĐBSCL cần sớm có các biện pháp chủ động phòng chống.

“Chìa khóa” kéo dài thời gian lưu trú của du khách tới Đà Nẵng là đây
SK&MT - Bật mí với phóng viên, ông Lương Duy Doanh – Giám đốc FiveStar Travel cho biết: “Mỗi mùa Lễ hội Pháo hoa quốc tế Đà Nẵng (DIFF), lượng du khách tới Đà Nẵng qua FiveStar Travel lại tăng cao. Đặc biệt, 3 năm gần đây, khách đi tour trọn gói qua FiveStar Travel những ngày diễn ra DIFF tăng từ 10-20% so với ngày thường. Trong khi đó, khách đặt dịch vụ đơn lẻ như vé máy bay, phòng khách sạn tăng tới khoảng 30%”.

Xanh ngát FLC Tropical City Ha Long
SK&MT - Ngày 30/3/2019, Tập đoàn FLC đã tổ chức lễ phát động chiến dịch Go Green 2019 tại dự án FLC Tropical City Ha Long, khởi đầu hành trình tái tạo lá phổi xanh trên khắp cả nước, góp phần kiến tạo không gian sống bền vững và gần gũi với thiên nhiên cho các cư dân hiện đại.

Công bố vaccine giúp đẩy lùi các dạng ung thư ruột
SK&MT - Một loại vaccine mới có thể giúp đẩy lùi các dạng ung thư ruột, bao gồm ung thư ruột kết và ung thư trực tràng do Weill Cornell Medicine College (Mỹ) sáng chế vừa được công bố.

Những công dụng tuyệt vời từ hạt Chia
SK&MT – Hạt chia là một loại thực phẩm tuy nhỏ bé nhưng lại có nguồn năng lượng và tác dụng to lớn đối với cơ thể con người. Trong hạt chia có chứa hàm lượng axit béo omega-3 khá cao, giúp tăng HDL cholesterol giúp bảo vệ và chống lại các bệnh tim mạch và đột quỵ và một số những công dụng tuyệt vời khác mà chúng ta cần biết.

Tập đoàn FLC lan tỏa hành trình tái tạo “lá phổi xanh”
SK&MT - Tiếp nối thành công Go Green mùa trước của Tập đoàn FLC, chiến dịch"Go Green 2019" đang tái khởi động với hơn 10.000 cây xanh sẽ tiếp tục được phủ xanh hệ thống quần thể FLC. Sự kiện này được phát động đầu tiên tại FLC Tropical City Ha Long, sau đó triển khai đồng loạt trên 5 tỉnh thành khác.

Khu vực Nam Á chiếm 18/20 thành phô ô nhiễm không khí nhất năm 2019
SK&MT - Theo một bản nghiên cứu mới do 2 tổ chức là Hòa bình Xanh và AirVisual công bố trong hôm 5/3, Ấn Độ là đất nước có tới 7 trong tổng số 10 thành phố có mức độ ô nhiễm không khí nghiêm trọng nhất thế giới. Trong khi đó, nhiều thành phố của Trung Quốc có chất lượng không khí được cải thiện đáng kể.

